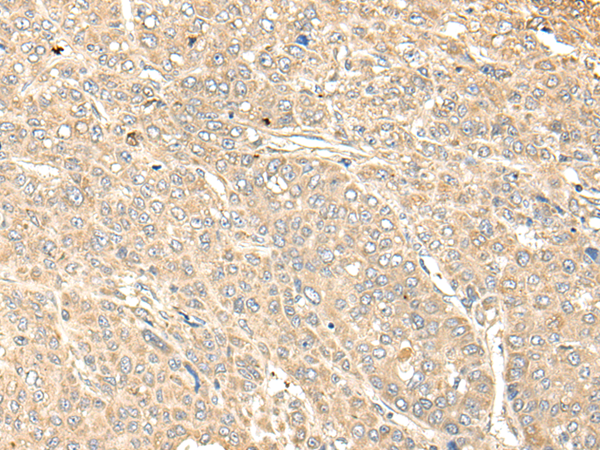

手機(jī)掃碼訪問(wèn)本站

微信咨詢(xún)
品牌:
貨號(hào):JN15462
規(guī)格: 100ul 200ul 25ul
聯(lián)系方式:021-54721350
|
Background: |
WDFY4 is predominantly expressed in the immune tissues. The function of WDFY4 is not well known; |
|
Applications: |
ELISA, IHC |
|
Name of antibody: |
WDFY4 |
|
Immunogen: |
Fusion protein of human WDFY4 |
|
Full name: |
WDFY family member 4 |
|
Synonyms: |
C10orf64 |
|
SwissProt: |
Q6ZS81 |
|
ELISA Recommended dilution: |
5000-10000 |
|
IHC positive control: |
Human liver cancer |
|
IHC Recommend dilution: |
40-200 |